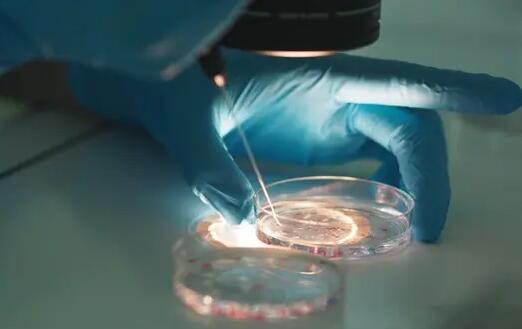
廣西供卵試管 2023廣西壯族自治區試管嬰兒醫院費用一覽表，附試管助孕費用花費明細參考 ‘15周股骨長多少是男孩’

廣西供卵試管 2023 廣西壯族自治區試管嬰兒醫院費用一覽表,附試管助孕費用花
廣西供卵試管擁有權威的育嬰師、助孕、母嬰護理和育兒嫂等培訓項目,正規專業的供卵服務網站,14年的用心經營,幫助你實現生子夢想!
2022廣西壯族自治區試管嬰兒醫院費用一覽表,附試管助孕費用花費明細參考
2022廣西壯族自治區經衛健委批準開展試管嬰兒的醫院有不少,像聯勤保障部隊第924醫院、柳州市婦幼保健院、廣西壯族自治區婦幼保健院等都是省內開展輔助生殖技術醫院中的出類拔翠。但是眾所周知的是,試管嬰兒費用并不便宜,不少患者在決定做試管嬰兒前都會進行相關的了解。2022廣西壯族自治區試管嬰兒醫院費用一般在3-15萬元左右,總花費明細參考如下。
2022廣西壯族自治區試管嬰兒醫院費用一覽表

1、術前的檢查(1000-3000元)
一般在進行試管嬰兒治療前,夫婦雙方要進行術前檢查,主要是排除一些不適合進行試管嬰兒的疾病如傳染性疾病和不適合女方懷孕的疾病。
2、試管嬰兒的藥費(9000-20000元)
試管嬰兒是通過藥物促排卵后取出女方的卵子的,一般要使用20-40支的促排卵藥物,而且藥物還會為國產和進口,這在一步前還需要使用降調節藥物,根根促排方案不同,所用到的藥量是不一樣的,而且產生的費用也是有差異的。
3、取卵手術費用(3000元左右)
當促排卵過程結束后,就需要在B超引導下進行采卵手術,取卵手術很快大概在5分鐘左右即可完成。但是由于取精后不能立即使用,精子必須經過特殊方法和程序進行優化優選,挑選出強壯有力的合格優質精子進行授精,這樣才可以提高精卵受精率,繼而提高試管嬰兒成功率。
4、實驗室培養胚胎(6000-30000元左右)
取卵取精后,需要在實驗室進行胚胎培養,費用大約6000元左右,進行第二代試管嬰兒需要進行單精子注射,會增加5000元左右的費用。第三代試管嬰兒如果要進行基因篩查,會增加20000元左右的費用。
5、胚胎移植(3000-10000元左右)
胚胎移植這個步驟看似幾分鐘就完成很簡單,但是其專業性不可小視,首先要內膜厚度合格才可以移植,還有胚胎放入的位置等都是有講究的,而且還會分為鮮胚移植和凍胚移植,兩者的費用也是不同的。
2022試管助孕費用花費明細參考
實例參考1、我在聯勤保障部隊第924醫院做的三代試管,一共花了9萬左右,進行了兩次的移植,費用明細為:前期檢查中我花了3500元,丈夫花了2000元,然后B超監測排卵花了550元,降調和促排卵藥費35000元。之后我取卵,丈夫取精后一起送去受精、培養了,43500元,移植手術8000元。
實例參考2、我是來自桂林的許女士,丈夫患者無精癥做的是二代試管,總共花了65000元左右,其中有身體檢查費是5500元左右,藥物費20000元左右、取精費7000元左右、胚胎培養費20000元左右、移植費15000元左右、驗孕費200元左右,
實例參考3、我是來自玉林的胡女士,我是高齡試管助孕,由于卵巢功能弱進行了三次捉排卵后才取到一個周期試管的卵子用量的,進行了兩次移植,總共花費了80000左右,具體是術前身體檢查費10000左右,其中含用宮頸炎治療的費用,促排卵35000元,用的是進口的藥,再就是取卵、取精、培養大概花了25000元,移植費用在10000左右。
總結
2022廣西壯族自治區各大試管嬰兒醫院的費用都是大同小異的,由于是公立醫院通常收費是明碼標價的,而且價格都是經物價局進行審核過的了,因此患者們不用擔心多花錢。但是由于公立醫院每天的就診患者很多,導致就醫體驗感很差,因此不少的患者選擇在服務好的醫療機構內進行助孕,但由于不良機構參于其中,大家在選擇時要注意仔細甄別。
2022廣西壯族自治區婦幼保健院試管嬰兒生男孩費用、成功率一覽
在廣西壯族自治區婦幼保健院做一次試管嬰兒的費用約為3-12萬元,做試管嬰兒的費用主要包括術前檢查費用、促排卵藥物及卵泡監測費用、取卵手術和胚胎培養費用以及胚胎移植的相關費用,不同情況做試管嬰兒的費用也會有所不同,具體如下:
在廣西壯族自治區婦幼保健院做試管嬰兒的成功率約為30%-55%,但隨著女性年齡的增長,成功率逐漸呈下降趨勢。30歲以下的女性做試管嬰兒的成功率能達到55%以上,30-35歲的女性做試管嬰兒的成功率在45%以上,35-40歲的女性做試管嬰兒的成功率在35%以下,40-45歲的女性,做試管嬰兒的成功率只有20%左右。
以上就是“2022廣西壯族自治區婦幼保健院試管嬰兒生男孩費用、成功率一覽”的全部內容了,上述成功率和費用并不是絕對的,因為每個人的實際情況都不同,所以做試管嬰兒的成功率和費用都會有所不同。女性年齡越大,做試管嬰兒的成功率就越低,費用也會增加。因此,如果想提高試管嬰兒的成功率,減少費用支出,建議盡早做試管嬰兒手術。
如果想了解更多試管醫院關于試管嬰兒費用、成功率的有關信息,也可以添加生殖顧問的微信,進行免費咨詢。
2022廣西壯族自治區生殖醫院前十排名公布,附試管費用估算及成功率
全國有育齡夫婦約2.3億人,不孕不育發生率大概在15%到20%,也就是說至少有一千萬個家庭受生育難題的困擾,而輔助生殖技術正好確決了這一難題,讓不少的患者家庭實現了生育之夢。截止目前在廣西壯族自治區內由國家衛健委批準運行輔助生殖技術的生殖醫院一共有21家,那么關于“廣西壯族自治區生殖醫院前十排名”“試管費用多少”“試管成功率多少”等問題,下面就來詳細介紹。
2022廣西壯族自治區生殖醫院前十排名公布
一、廣西壯族自治區婦幼保健院
廣西壯族自治區婦幼保健院建立于1965年1月,歷經50多年的發展,現已成為集保健、醫療、科研、教學和基層婦幼保健指導為一體的三級甲等婦幼保健院和愛嬰醫院,并形成廣西婦幼保健院、廣西婦產醫院、廣西兒童醫院、廣西出生缺陷預防控制研究所三院一所兩院區的格局,設置有孕產保健部、兒童保健部、婦女保健部、門診醫技部及行政后勤部五大部門。
準入技術:夫精人工授精技術、供精人工授精技術、常規體外受精-胚胎移植技術、卵胞漿內單精子顯微注射技術、植入前胚胎遺傳學診斷技術。
試管成功率:50%-65%左右。
試管費用:一、二代試管嬰兒費用在4-6萬左右,三代試管嬰兒費用在6-12萬左右,具體費用因人而異,僅供參考。
二、聯勤保障部隊第924醫院
坐落在桂林市象鼻山下、漓江之濱的第九二四醫院(原解放軍第一八一醫院),組建于1946年,經過70年的建設發展,現已成為一所集醫療、教學、科研和預防、康復、保健為一體的現代化綜合性“三級甲等”醫院。醫院占地面積9萬多平方米,建筑面積12萬多平方米,展開床位1000余張。
準入技術:夫精人工授精技術、供精人工授精技術、常規體外受精-胚胎移植技術、卵胞漿內單精子顯微注射技術、植入前胚胎遺傳學診斷技術。
試管成功率:50%-60%左右。
試管費用:一、二代試管嬰兒費用在4-6萬左右,三代試管嬰兒費用在6-12萬左右,具體費用因人而異,僅供參考。
三、柳州市婦幼保健院
柳州市婦幼保健院(柳州市兒童醫院、柳州市婦產醫院、柳州市婦幼保健計劃生育服務中心)是一所集保健、醫療、康復、科研、教學為一體的三級甲等婦幼保健機構,有城中和柳東兩個院區,為柳州市及周邊地區婦女兒童提供婦幼健康服務,并承擔全市婦幼衛生及計劃生育技術服務業務管理和技術支持工作和120急救任務,是廣西科技大學附屬婦兒臨床醫學院及廣西科技大學附屬婦產醫院、兒童醫院,桂林醫學院教學醫院。
準入技術:夫精人工授精技術、供精人工授精技術、常規體外受精-胚胎移植技術、卵胞漿內單精子顯微注射技術、植入前胚胎遺傳學診斷技術。
試管成功率:50%以上。
試管費用:一、二代試管嬰兒費用在4-6萬左右,三代試管嬰兒費用在6-12萬左右,具體費用因人而異,僅供參考。
四、南寧市第二人民醫院
南寧市第二人民醫院(廣西醫科大學第三附屬醫院、廣西醫科大學第三臨床醫學院)始建于1952年,是一所集醫療、急救、教學、科研、預防、保健、康復為一體的三級甲等綜合性醫院。2019年9月,醫院醫療集團成立,包括院本部、市婦產兒童醫院、市第二婦幼保健院、五象醫院、江南區人民醫院、良慶區人民醫院、空港醫院、良慶鎮中心衛生院、蟠龍西社區衛生服務中心、福建園社區衛生服務中心、大沙田街道前進社區衛生服務中心、延安鎮衛生院。
準入技術:夫精人工授精技術、供精人工授精技術、常規體外受精-胚胎移植技術、卵胞漿內單精子顯微注射技術。
試管成功率:50%以上。
試管費用:一、二代試管嬰兒費用在4-8萬左右,具體費用因人而異,僅供參考。
五、廣西醫科大學第一附屬醫院
廣西醫科大學第一附屬醫院創建于1934年,是廣西首家三級甲等綜合醫院,廣西臨床醫療、醫學教育、醫學研究、醫療保健的中心。是全國文明單位、全國衛生計生系統先進集體、全國百佳醫院、全國百姓放心示范醫院、全國人文愛心醫院、全國愛嬰醫院;是中國—東盟醫院合作聯盟主席單位、中國—東盟醫學人才培養合作單位。
準入技術:夫精人工授精技術、常規體外受精-胚胎移植技術、卵胞漿內單精子顯微注射技術。
試管成功率:50%以上。
試管費用:一、二代試管嬰兒費用在4-8萬左右,具體費用因人而異,僅供參考。
六、廣西壯族自治區生殖醫院
廣西壯族自治區生殖醫院(廣西壯族自治區生殖健康研究中心)隸屬于自治區衛生健康委,是廣西唯一公立三級生殖專科醫院,是廣西人類輔助生殖技術管理中心掛靠單位。醫院是廣西業務量領先、極具影響力的生殖醫療機構,已成為廣大不孕不育夫婦圓夢的搖籃。
準入技術:夫精人工授精技術、常規體外受精-胚胎移植技術、卵胞漿內單精子顯微注射技術。
試管成功率:50%以上。
試管費用:一、二代試管嬰兒費用在4-8萬左右,具體費用因人而異,僅供參考。
七、廣西壯族自治區人民醫院
廣西壯族自治區人民醫院創建于1941年,是自治區人民政府主辦、自治區衛生健康委直屬的廣西規模最大的三級甲等公立醫院,2021年5月獲批掛牌廣西醫學科學院,承擔醫療、科研、教學、預防、保健、康復和健康管理等工作任務。已形成“兩院三區四門診”格局,“兩院”即廣西醫學科學院和廣西壯族自治區人民醫院,“三區”即桃源院區、東院院區和北院院區,“四門診”即桃源院區門診、東院院區門診、北院院區門診以及外設門診星湖門診,編制床位數3755張,在職職工5600多人。2020年,門急診診療、服務患者214.27萬人次,出院病人8萬人次。先后榮獲全國衛生系統先進集體、全國抗擊新冠肺炎疫情先進集體、自治區主席質量獎提名獎(排名第一)、八桂楷模等多項榮譽。
準入技術:夫精人工授精技術、常規體外受精-胚胎移植技術、卵胞漿內單精子顯微注射技術。
試管成功率:50%左右。
試管費用:一、二代試管嬰兒費用在4-8萬左右,具體費用因人而異,僅供參考。
八、桂林市婦幼保健院
桂林市婦幼保健院(桂林市婦女兒童醫院)是一所具有綜合實力的三級甲等婦幼保健機構,是由市婦幼保健院與市第四人民醫院(原桂林地區人民醫院)合并而成的百年醫院。桂林市婦幼保健院始建于1911年,有110年發展歷史,其前身為英國基督教會桂林道生醫院,是桂林市第一所西醫醫院、廣西壯族自治區最早建立的婦幼保健院。桂林市第四人民醫院(原桂林地區人民醫院)始建于1951年,2000年增掛桂林市紅十字會博愛醫院。2006年6月,兩院合并成為桂林市婦女兒童醫院(桂林市婦幼保健院)。
準入技術:夫精人工授精技術、常規體外受精-胚胎移植技術、卵胞漿內單精子顯微注射技術。
試管成功率:50%左右。
試管費用:一、二代試管嬰兒費用在4-8萬左右,具體費用因人而異,僅供參考。
九、柳州市人民醫院
柳州市人民醫院創建于1926年,是集醫療、教學、科研、預防、保健、康復為一體的三級甲等綜合醫院,是廣西醫科大學附屬柳州市人民醫院,廣西醫科大學柳人臨床醫學院、是全國文明單位、國家第一批住院醫師規范化培訓基地、國家臨床藥師培訓基地、第一批全科醫生規范化培養基地、國家合理用藥示范基地,感染性疾病科獲國家臨床重點專科建設項目,口腔全科專業基地是國家住院醫師規范化培訓重點專業基地,是五星級綠色環保醫院,是全國建立健全現代醫院管理制度試點醫院。
準入技術:夫精人工授精技術、常規體外受精-胚胎移植技術、卵胞漿內單精子顯微注射技術。
試管成功率:50%左右。
試管費用:一、二代試管嬰兒費用在4-8萬左右,具體費用因人而異,僅供參考。
十、桂林醫學院附屬醫院
桂林醫學院附屬醫院創建于1958年5月,是一所集醫療、教學、科研、預防、康復、急救為一體的綜合性三級甲等醫院、國際緊急救援中心網絡醫院和國際SOS急救中心、國家藥物臨床試驗基地、國家衛健委首批住院醫師規范化培訓基地、全國縣級醫院血液凈化培訓基地、中國胸痛中心認證醫院、中國卒中中心聯盟單位、廣西臨床病理質量控制中心及桂林診斷中心、廣西地中海貧血產前診斷分中心等。
準入技術:夫精人工授精技術、常規體外受精-胚胎移植技術、卵胞漿內單精子顯微注射技術。
試管成功率:50%左右。
試管費用:一、二代試管嬰兒費用在4-8萬左右,具體費用因人而異,僅供參考。
總結
以上就是2022廣西壯族自治區生殖醫院前十排名,其中關于做試管的成功率和費用估算也為大家介紹到了,大家可以根據自身情況進行選擇。對于選擇生殖醫院除了看成功率之外,還需要結合其它的各個方面來進行挑選,如就醫體驗、服務狀況、等待時間、就近原則、醫療技術、醫師力量、醫療設備等情況進行全面的了解后,再結合自身的病情選擇最適合的醫院是最好的。當然,在公立醫院受接輔助生殖項目,必需要達到規定的指征,否則是不接受的。那么對于確實有需求只能選擇醫療機構進行,但是因為醫療機構參差不齊需謹慎選擇。
溫馨提示
對于試管移植后是否可以喝蜂蜜柚子茶這個問題,醫生的回答是:可以。試管移植后的產婦需要注意保持良好的生活習慣,飲食清淡、營養均衡,避免吃辛辣刺激性食物,但可以適量飲用蜂蜜柚子茶。
三、蜂蜜柚子茶的注意事項
盡管試管移植后可以喝蜂蜜柚子茶,但是還是需要注意一些事項。首先,蜂蜜柚子茶中含有柚子皮苷,這種物質會影響人體對藥物的代謝和吸收,因此產婦在服用藥物時需要咨詢醫生的意見。其次,蜂蜜柚子茶中含有大量的糖分,產婦在飲用時需要注意控制糖分的攝入量,避免引起血糖升高。
綜上所述,試管移植后可以適量飲用蜂蜜柚子茶,但需要注意控制糖分的攝入和咨詢醫生的意見,以保證身體健康和試管移植的成功。
tips
Tips:
其實,若是著床出血,還是很好辨認的,因為這時的出的血顏色為淺淡的粉色或褐色,形狀呈“條紋狀”,不過由于女性自身體質的不同,部分女性即使是著床后出血,其顏色也不一定為粉色或褐色,但其鮮胚卻是實實在在的著床了。
